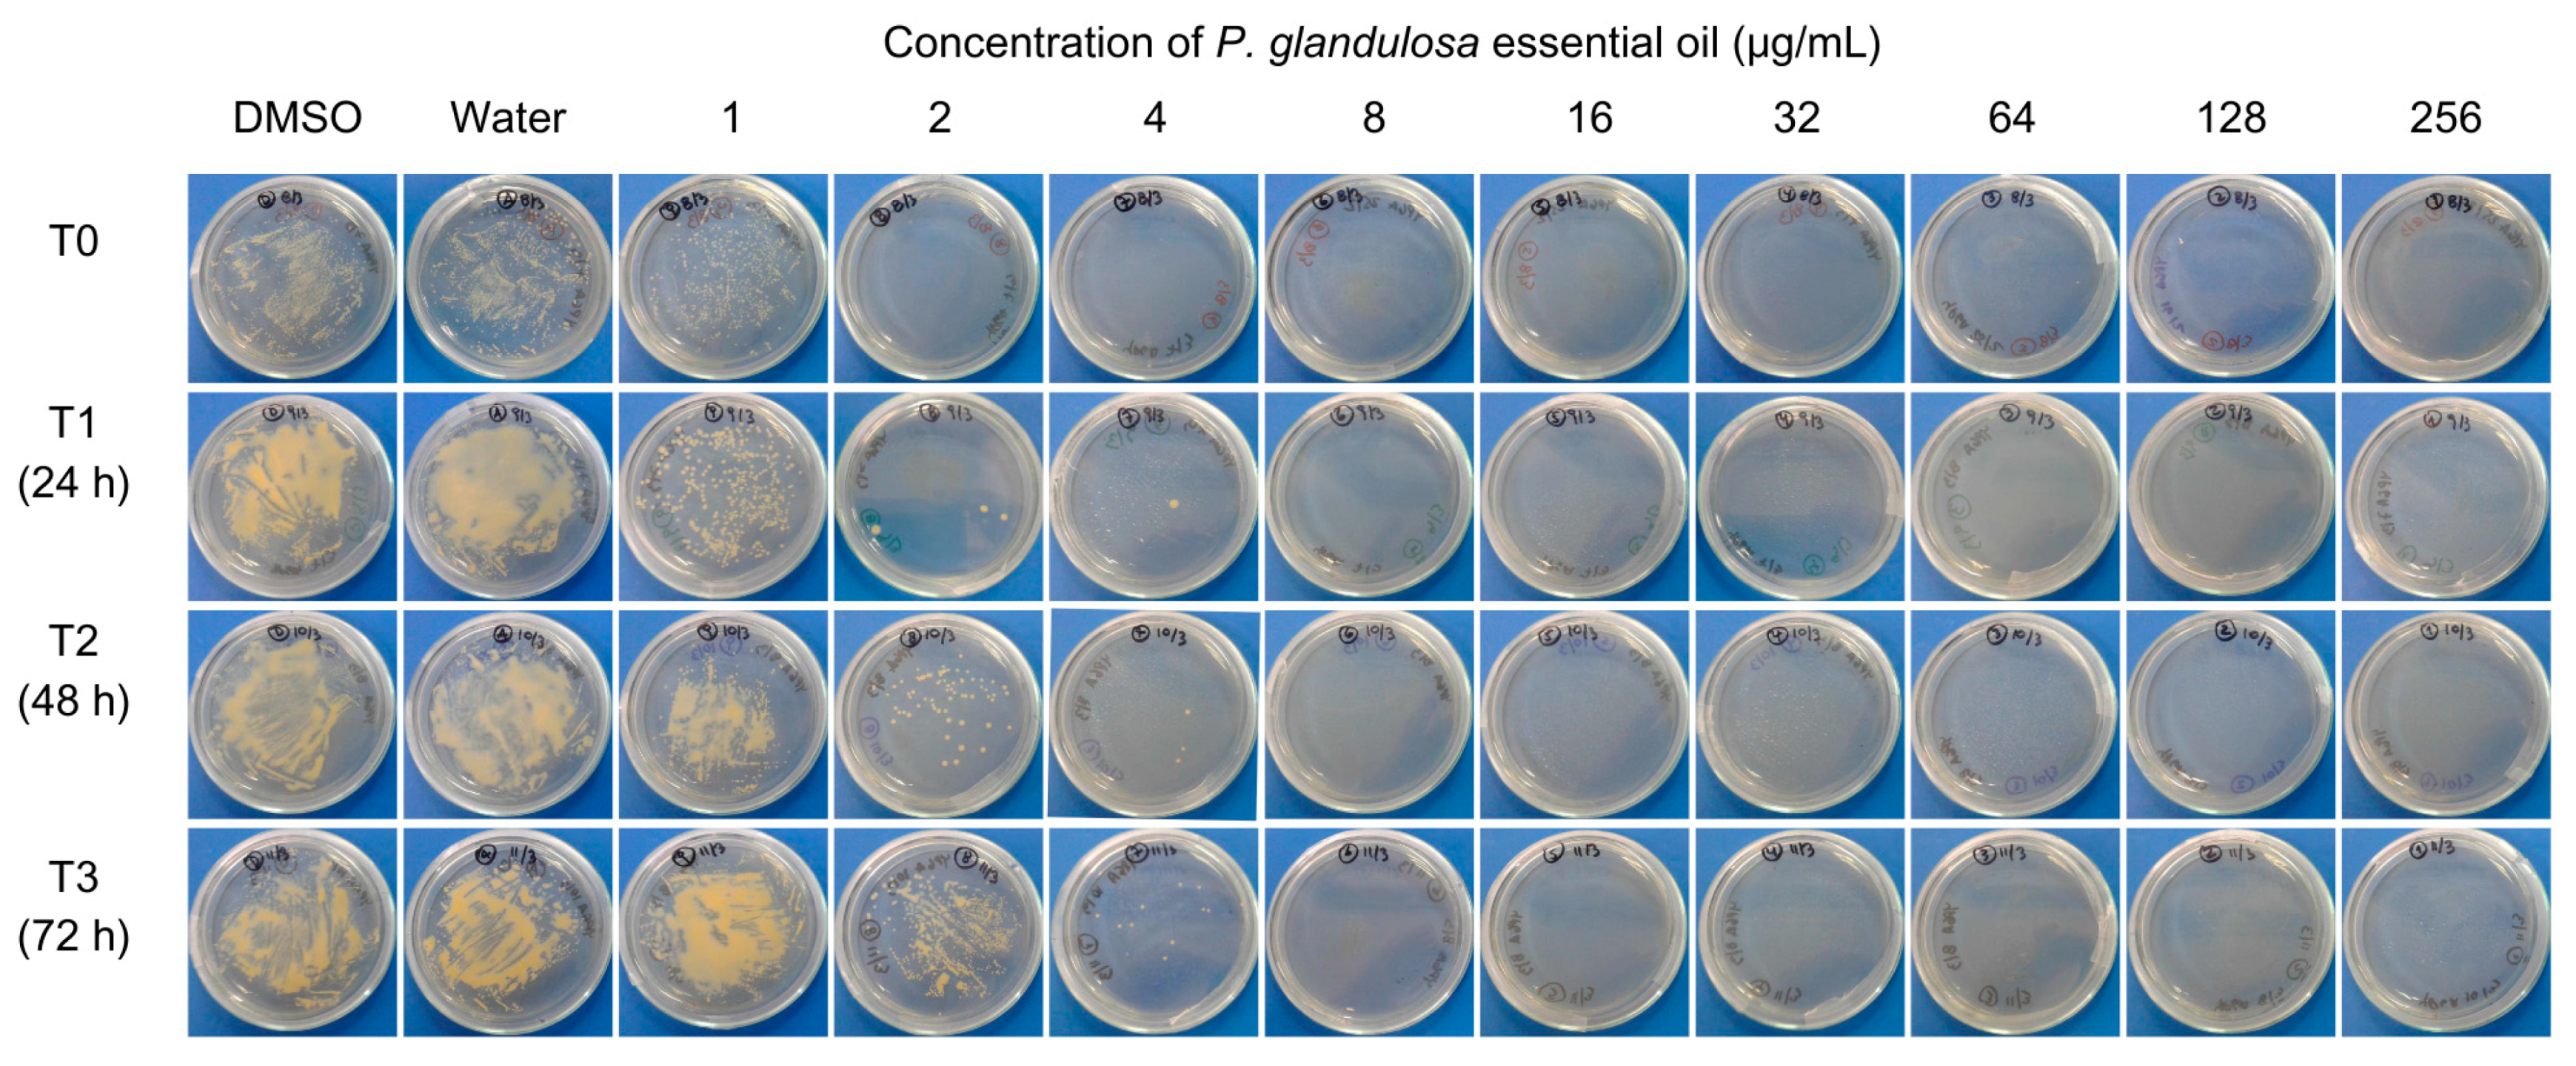
Agronomy 14 02615 g001
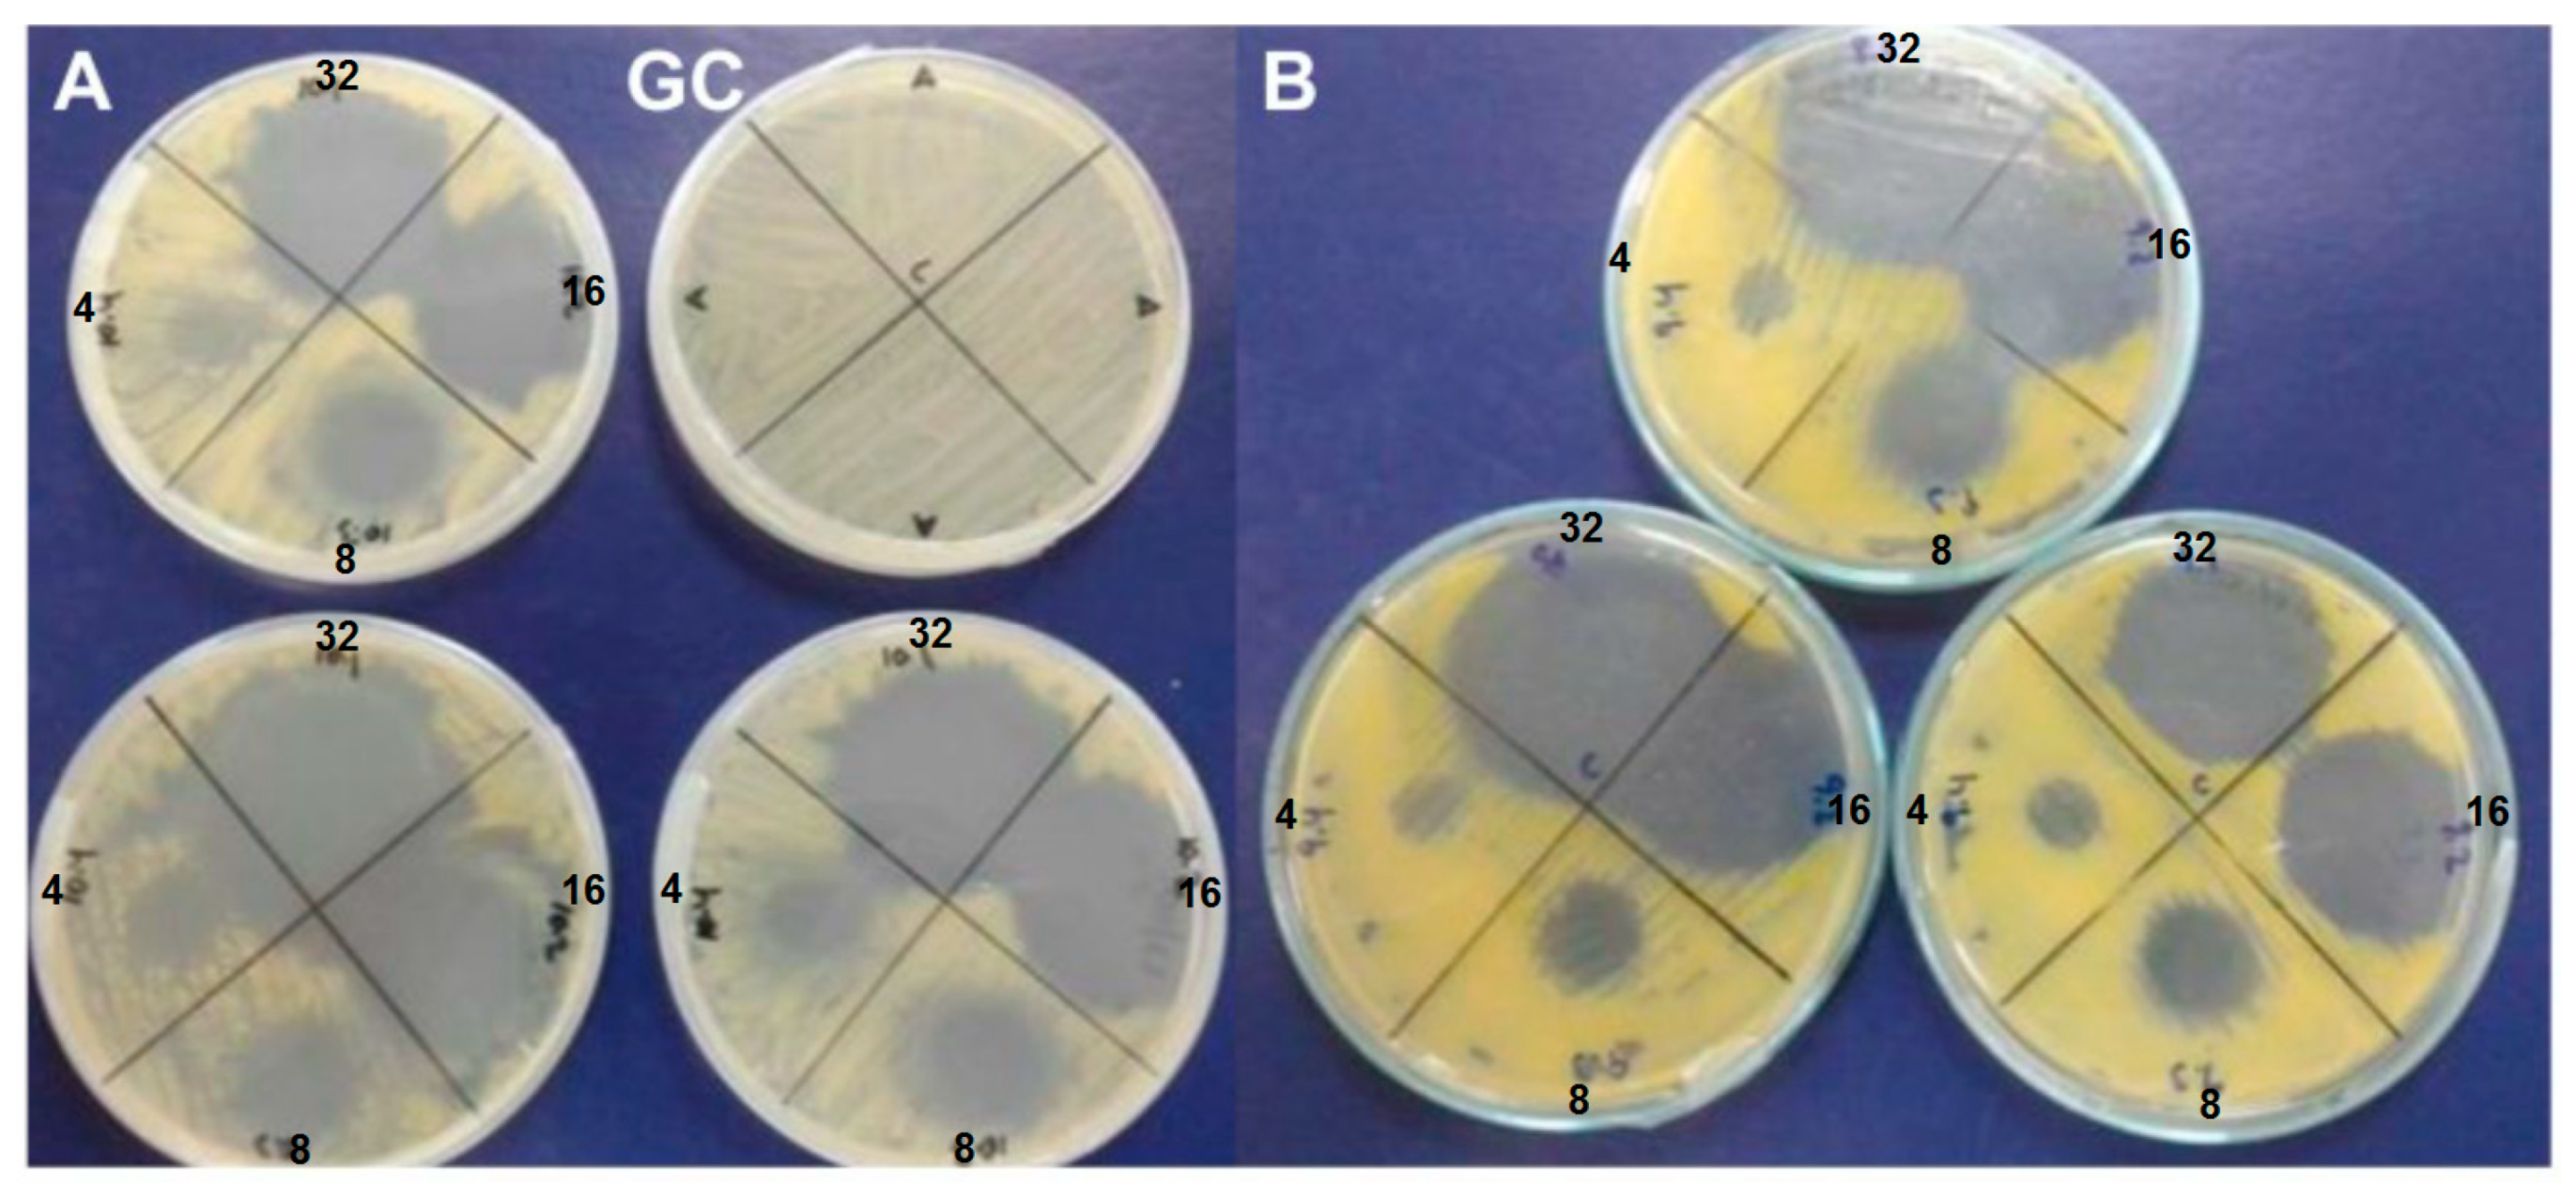
Agronomy 14 02615 g002

Natural Bactericidal Effects of Psoralea glandulosa Essential Oil for the Control of Bacterial Canker and Speck in Tomato
Abstract
1. Introduction
2. Materials and Methods
2.1. Standards and Solvents
2.2. Plant Material and Extraction of Essential Oil
2.3. Chromatographic Analysis
2.4. Isolation of Bakuchiol
2.5. In Vitro Antibacterial Assay
2.5.1. Strains
2.5.2. Antibacterial Activity Assay
2.6. Drop Test
2.7. Statistical Analysis
3. Results and Discussion
3.1. Extraction and Characterization of the Essential Oil
3.2. In Vitro Antibacterial Assay
4. Conclusions
Author Contributions
Funding
Data Availability Statement
Acknowledgments
Conflicts of Interest
References
- Bhandari, R.; Neupane, N.; Adhikari, D.P. Climatic Change and Its Impact on Tomato (Lycopersicum esculentum L.) Production in Plain Area of Nepal. Environ. Chall. 2021, 4, 100129. [Google Scholar] [CrossRef]
- Worldwide (Total Fresh) Tomato Production in 2021. Available online: https://www.tomatonews.com/en/worldwide-total-fresh-tomato-production-in-2021_2_1911.html (accessed on 9 September 2024).
- Food and Agriculture Organization of the United Nations (2023)—With Major Processing by Our World in Data. “Tomato Production—FAO” [Dataset]. Food and Agriculture Organization of the United Nations, “Production: Crops and Livestock Products” [Original Data]. Available online: https://ourworldindata.org/grapher/tomato-production (accessed on 3 October 2024).
- Prasanna, H.; Rai, N.; Hussain, Z.; Yerasu, S.R.; Tiwari, J.K. Tomato: Breeding and Genomics. ISVS 2023, 50, 146–155. [Google Scholar] [CrossRef]
- Richard, B.; Qi, A.; Fitt, B.D.L. Control of crop diseases through integrated crop management to deliver climate-smart farming systems for low- and high-input crop production. Plant Pathol. 2022, 71, 187–206. [Google Scholar] [CrossRef]
- Panno, S.; Davino, S.; Caruso, A.G.; Bertacca, S.; Crnogorac, A.; Mandić, A.; Noris, E.; Matić, S. A Review of the Most Common and Economically Important Diseases That Undermine the Cultivation of Tomato Crop in the Mediterranean Basin. Agronomy 2021, 11, 2188. [Google Scholar] [CrossRef]
- Butsenko, L.; Pasichnyk, L.; Kolomiiets, Y.; Kalinichenko, A. The Effect of Pesticides on the Tomato Bacterial Speck Disease Pathogen Pseudomonas syringae pv. Tomato. Appl. Sci. 2020, 10, 3263. [Google Scholar] [CrossRef]
- De León, L.; Siverio, F.; López, M.M.; Rodríguez, A. Clavibacter michiganensis subsp. michiganensis a seedborne tomato pathogen: Healthy Seeds are still the goal. Plant Dis. 2011, 90, 1328–1338. [Google Scholar] [CrossRef]
- Sen, Y.; van der Wolf, J.; Visser, R.; va Exuden, R. Bacterial canker of tomato: Current knowledge of detection, management resistance, and interactions. Plant Dis. 2015, 99, 4–13. [Google Scholar] [CrossRef]
- Lyu, Q.; Bai, K.; Kan, Y.; Jiang, N.; Thapa, S.P.; Coaker, G.; Li, J.; Luo, L. Variation in Streptomycin Resistance Mechanisms in Clavibacter michiganensis. Phytopathology 2019, 109, 1849–1858. [Google Scholar] [CrossRef]
- Valenzuela, M.P. Caracterización de cepas del fitopatógeno de tomate Clavibacter michiganensis subsp. michiganensis aisladas en Chile y estudio de estrategias de biocontrol. Ph.D. Thesis, Universidad Técnica Federico Santa María, Valparaíso, Chile, 14 January 2019. [Google Scholar]
- Griffin, K.; Gambley, C.; Brown, P.; Li, Y. Copper-tolerance in Pseudomonas syringae pv. tomato and Xanthomonas spp. and the control of diseases associated with these pathogens in tomato and pepper. A systematic literature review. Crop Prot. 2017, 96, 144–150. [Google Scholar] [CrossRef]
- Besoain, X.; Chahuán, J. Sensibilidad de diez cepas de Clavibacter michiganensis subsp. michiganensis a Kasugamicin. XVII Congreso Chileno de Fitopatología, Concepción-Chile. Available online: http://www.sochifit.cl/pdf/XVII.pdf (accessed on 2 September 2024).
- Gupta, I.; Singh, R.; Muthusamy, S.; Sharma, M.; Grewal, K.; Singh, H.P.; Batish, D.R. Plant Essential Oils as Biopesticides: Applications, Mechanisms, Innovations, and Constraints. Plants 2023, 12, 2916. [Google Scholar] [CrossRef]
- Alonso-Gato, M.; Astray, G.; Mejuto, J.C.; Simal-Gandara, J. Essential Oils as Antimicrobials in Crop Protection. Antibiotics 2021, 10, 34. [Google Scholar] [CrossRef] [PubMed]
- Biopesticides Market Soon to Hit $3.4 Billion. Available online: https://www.farmprogress.com/management/biopesticides-market-soon-to-hit-3-4-billion (accessed on 9 September 2024).
- Madrid, A.; Silva, V. Past, Present and Future of Psoralea glandulosa Linn, Chilean Medicinal Plant, an Inexhaustible Resource: A Literature Review. BLACPMA 2024, 23, 336–348. [Google Scholar] [CrossRef]
- Madrid, A.M.; Espinoza, L.J.; Mellado, M.A.; Osorio, M.E.; Montenegro, I.J.; Jara, C.E. Evaluation Of The Antioxidant Capacity Of Psoralea glandulosa L. (Fabaceae) Extracts. J. Chil. Chem. Soc. 2012, 57, 1328–1332. [Google Scholar] [CrossRef]
- Madrid, A.; Cardile, V.; González, C.; Montenegro, I.; Villena, J.; Caggia, S.; Graziano, A.; Russo, A. Psoralea glandulosa as a Potential Source of Anticancer Agents for Melanoma Treatment. Int. J. Mol. Sci. 2015, 16, 7944–7959. [Google Scholar] [CrossRef] [PubMed]
- Nadine Backhouse, C.; Delporte, C.L.; Negrete, R.E.; Erazo, S.; Zuñiga, A.; Pinto, A.; Cassels, B.K. Active Constituents Isolated from Psoralea glandulosa L. with Antiinflammatory and Antipyretic Activities. J. Ethnopharmacol. 2001, 78, 27–31. [Google Scholar] [CrossRef]
- Madrid Villegas, A.; Díaz Peralta, K.; González Tapia, C.; Catalán Marín, K.; Espinoza Catalán, L. Antiphytopathogenic Activity of Psoralea glandulosa (Fabaceae) against Botrytis cinerea and Phytophthora cinnamomi. Nat. Prod. Res. 2015, 29, 586–588. [Google Scholar] [CrossRef]
- Becerra, J.; Bittner, M.; Hernández, V.; Brintrup, C.; Becerra, J.; Silva, M. Actividad de aceites esenciales de Canelo, Queule, Bailahuén y Culén frente a hongos fitopatógenos. BLACPMA 2010, 9, 212–215. [Google Scholar]
- Kant, R.; Kumar, A. Review on Essential Oil Extraction from Aromatic and Medicinal Plants: Techniques, Performance and Economic Analysis. Sustain. Chem. Pharma. 2022, 30, 100829. [Google Scholar] [CrossRef]
- Adams, P.R. Identification of Essential Oil Components by Gas Chromatography/Mass Spectromety, 4th ed.; Allured Publishing Corp.: Carol Stream, IL, USA, 2007. [Google Scholar]
- De León, L.; Siverio, F.; López, M.M.; Rodríguez, A. Comparative Efficiency of Chemical Compounds for in Vitro and in Vivo Activity against Clavibacter Michiganensis Subsp. Michiganensis, the Causal Agent of Tomato Bacterial Canker. Crop Prot. 2008, 27, 1277–1283. [Google Scholar] [CrossRef]
- Pasteran, F.; Danze, D.; Cabrera, C.; Lucero, C.; Menocal, A.; Albornoz, E.; Castillo, I.; Rapoport, M.; Ceriana, P.; Gagetti, P.; et al. Development and validation of simple tests (agar spot, colistin drop, 1ml-broth disk elution MIC and tablet pre-diffusion) as an alternative to improve accuracy in screening chromosomal and plasmid-mediated colistin resistance in Gram-negative bacilli F. In Proceedings of the European Congress of Clinical Microbiology and Infectious Diseases (ECCMID) 2018, Madrid, Spain, 21–24 April 2018. Abstract O0952. [Google Scholar]
- Khan, M.H.; Dar, N.A.; Alie, B.A.; Dar, S.A.; Lone, A.A.; Mir, G.H.; Fayaz, U.; Ali, S.; Tyagi, A.; El-Sheikh, M.A.; et al. Unraveling the Variability of Essential Oil Composition in Different Accessions of Bunium persicum Collected from Different Temperate Micro-Climates. Molecules 2023, 28, 2404. [Google Scholar] [CrossRef]
- Li, H.; Liu, J.; Liu, C.-F.; Li, H.; Luo, J.; Fang, S.; Chen, Y.; Zhong, R.; Liu, S.; Lin, S. Design, Synthesis, and Biological Evaluation of Membrane-Active Bakuchiol Derivatives as Effective Broad-Spectrum Antibacterial Agents. J. Med. Chem. 2021, 64, 5603–5619. [Google Scholar] [CrossRef] [PubMed]
- Nizam, N.N.; Mahmud, S.; Ark, S.M.A.; Kamruzzaman, M.; Hasan, M.K. Bakuchiol, a Natural Constituent and Its Pharmacological Benefits. F1000Res 2023, 12, 29. [Google Scholar] [CrossRef] [PubMed]
- Selestino Neta, M.C.; Vittorazzi, C.; Guimarães, A.C.; Martins, J.D.L.; Fronza, M.; Endringer, D.C.; Scherer, R. Effects of β-caryophyllene and Murraya paniculata essential oil in the murine hepatoma cells and in the bacteria and fungi 24-h time–kill curve studies. Pharm. Biol. 2017, 55, 190–197. [Google Scholar] [CrossRef] [PubMed]
- Coté, H.; Boucher, M.A.; Pichette, A.; Legault, J. Anti-inflammatory, antioxidant, antibiotic, and cytotoxic activities of Tanacetum vulgare L. essential oil and its constituents. Medicines 2017, 4, 34. [Google Scholar] [CrossRef]
- Jang, H.-I.; Rhee, K.-J.; Eom, Y.-B. Antibacterial and Antibiofilm Effects of α-Humulene against Bacteroides Fragilis. Can. J. Microbiol. 2020, 66, 389–399. [Google Scholar] [CrossRef]

| Nº | RT (min) | Components | % Area a | RI b | RI c | Identification |
|---|---|---|---|---|---|---|
| 1 | 17.49 | Caryophyllene | 3.70 | 1476 | 1476 | RL, MS, Co |
| 2 | 18.20 | α-humulene | 0.57 | 1480 | 1481 | RL, MS |
| 3 | 19.61 | δ-cadinene | 0.50 | 1524 | 1524 | RL, MS |
| 4 | 20.55 | Palustrol | 0.50 | 1550 | 1550 | RL, MS |
| 5 | 20.85 | Caryophyllene oxide | 3.41 | 1586 | 1586 | RL, MS, Co |
| 6 | 21.24 | Ledol | 0.28 | 1590 | 1593 | RL, MS |
| 7 | 21.36 | Humulene epoxide II | 0.30 | 1613 | 1614 | RL, MS |
| 8 | 21.92 | γ-muurolene | 0.87 | 1681 | 1682 | RL, MS |
| 9 | 29.99 | Bakuchiol | 85.42 | 2138 | 2138 | RL, MS, Co |
| Sample | CmVC533 | CmVLC78 | CmVQ59 | Pst | ||||
|---|---|---|---|---|---|---|---|---|
| MIC | MBC | MIC | MBC | MIC | MBC | MIC | MBC | |
| Bakuchiol | 16 | 32 | 32 | 32 | 2 | 4 | 256 | 256 |
| EO | 4 | 8 | 8 | 8 | 16 | 16 | 128 | 128 |
| Streptomycin | 2 | 4 | 2 | 4 | 4 | 4 | 128 | 256 |
| Mancozeb | 32 | 64 | 64 | 64 | 64 | 128 | 128 | 128 |
| Copper sulphate | 16 | 32 | 16 | 32 | 16 | 32 | 16 | 32 |
Disclaimer/Publisher’s Note: The statements, opinions and data contained in all publications are solely those of the individual author(s) and contributor(s) and not of MDPI and/or the editor(s). MDPI and/or the editor(s) disclaim responsibility for any injury to people or property resulting from any ideas, methods, instructions or products referred to in the content. |
© 2024 by the authors. Licensee MDPI, Basel, Switzerland. This article is an open access article distributed under the terms and conditions of the Creative Commons Attribution (CC BY) license (https://creativecommons.org/licenses/by/4.0/).
Share and Cite
Montenegro, I.; Valenzuela Ormeño, M.; Seeger, M.; Besoain, X.; Godoy, P.; Werner, E.; Caro, N.; Olguín, Y.; Valenzuela, M.; Silva, V.; et al. Natural Bactericidal Effects of Psoralea glandulosa Essential Oil for the Control of Bacterial Canker and Speck in Tomato. Agronomy 2024, 14, 2615. https://doi.org/10.3390/agronomy14112615
Montenegro I, Valenzuela Ormeño M, Seeger M, Besoain X, Godoy P, Werner E, Caro N, Olguín Y, Valenzuela M, Silva V, et al. Natural Bactericidal Effects of Psoralea glandulosa Essential Oil for the Control of Bacterial Canker and Speck in Tomato. Agronomy. 2024; 14(11):2615. https://doi.org/10.3390/agronomy14112615
Chicago/Turabian StyleMontenegro, Iván, Miryam Valenzuela Ormeño, Michael Seeger, Ximena Besoain, Patricio Godoy, Enrique Werner, Nelson Caro, Yusser Olguín, Manuel Valenzuela, Valentina Silva, and et al. 2024. "Natural Bactericidal Effects of Psoralea glandulosa Essential Oil for the Control of Bacterial Canker and Speck in Tomato" Agronomy 14, no. 11: 2615. https://doi.org/10.3390/agronomy14112615
APA StyleMontenegro, I., Valenzuela Ormeño, M., Seeger, M., Besoain, X., Godoy, P., Werner, E., Caro, N., Olguín, Y., Valenzuela, M., Silva, V., & Madrid, A. (2024). Natural Bactericidal Effects of Psoralea glandulosa Essential Oil for the Control of Bacterial Canker and Speck in Tomato. Agronomy, 14(11), 2615. https://doi.org/10.3390/agronomy14112615

